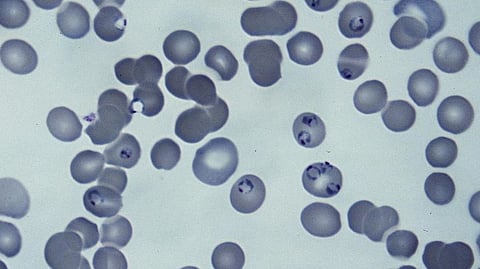

INDIANAPOLIS—Indiana University School of Medicine researchers have identified multiple species of bacteria that, when present in the gut, are linked to an increased risk of developing severe malaria in humans and mice. Their findings, recently published in Nature Communications, could lead to the development of new approaches targeting gut bacteria to prevent severe malaria and associated deaths.
Malaria is a life-threatening infectious disease caused by parasites transmitted through the bite of infected mosquitoes. According to the World Health Organization’s latest World Malaria Report, an estimated 619,000 people died from malaria globally in 2021, with 76% of those deaths occurring in children age 5 or younger.
IU School of Medicine’s Nathan Schmidt, PhD, an associate professor of pediatrics with the Ryan White Center for Pediatric Infectious Disease and Global Health and the Herman B Wells Center for Pediatric Research, said previous efforts to combat the disease have led to several advancements in malaria treatment and prevention, including new vaccines and antimalarial drugs, insecticides to manage mosquito populations and improved health care processes. However, he said new developments are desperately needed because the gains made in decreasing malaria-related deaths between the early 2000s and late 2010s have plateaued over the last five years.
In a pivotal 2016 article published in PNAS, Schmidt and his colleagues made a groundbreaking discovery in their experimental models: the gut microbiota has the capability to influence the severity of malaria. This revelation ignited their determination to pinpoint the precise microorganisms, called “Bacteroides,” within the intestinal tract that orchestrate this effect.
In their latest study, the researchers found mice harboring particular species of Bacteroides were notably associated with an elevated risk of severe malaria. A similar correlation was also observed in the intestinal tracts of children afflicted with severe malaria.
Most of the Schmidt lab’s research has been conducted using mouse models of malaria. Thanks to collaboration with several colleagues in the field, the research team was able to extend its observations by studying approximately 50 children with malaria in Uganda. They plan to continue their clinical observations by working with a cohort of over 500 children with malaria.
This collaboration was made possible by the joint efforts of Chandy John, MD, MS, of IU School of Medicine; Ruth Namazzi, MB ChB, MMEd, of Makerere University; and Robert Opoka, MD, MPH, of Global Health Uganda. Together, they are evaluating how severe malaria may affect child neurodevelopment by studying children from households with a history of severe malaria. While these children may not display any symptoms of illness, some carry the malaria parasite in their blood, allowing researchers to explore risk factors associated with the development of severe malaria, including variations observed in the microbiome.
“Dr. Namazzi, Dr. Opoka and I aren’t experts in the microbiome, so we collaborated with Nathan [Schmidt] on this part of the study since he is an expert,” said John, who is the Ryan White Professor of Pediatrics at IU School of Medicine. “I believe Nathan’s findings are important because they point to the possibility that certain bacteria or combinations of bacteria in the gut may predispose a child to severe malaria. This opens the way to thinking about how we might alter those combinations in the gut to try to protect children from severe malaria.”
In addition to studying the expanded cohort in Uganda, Schmidt and his team will also collaborate with researchers in Malawi and Mali to get a broader sense of trends present between gut microbiota and malaria across Africa.
“Beyond our efforts to assess the contribution of gut bacteria towards severe malaria in diverse African populations, we have initiated pre-clinical efforts to target gut bacteria that cause susceptibility to severe malaria,” Schmidt said. “Our long-term aspiration is to move a treatment into the clinic.”
About Indiana University School of Medicine
IU School of Medicine is the largest medical school in the U.S. and is annually ranked among the top medical schools in the nation by U.S. News & World Report. The school offers high-quality medical education, access to leading medical research and rich campus life in nine Indiana cities, including rural and urban locations consistently recognized for livability.(MV/Newswire)